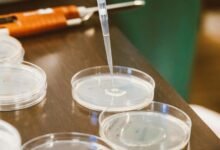
inbound call delay analysis

October 24, 2025
Themeshgame .Com – Explore the Latest in Mesh-Based Gaming
October 24, 2025
Earnstark Com – Unlock Earning Opportunities With Earnstark
October 24, 2025
Technikti. Com – Explore the Latest in Technology at Technikti
October 24, 2025